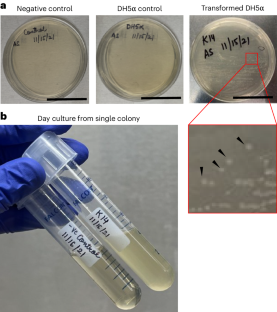

Abstract
Extracellular vesicles are a heterogeneous group of membrane-bound vesicles involved in cell–cell communication, formed at the plasma membrane (ectosomes) or by endocytosis (exosomes). Most exosome studies so far have focused on in vitro systems or exosomes derived from bodily fluids, while tissue-derived exosomes remain underexplored. Here we present a protocol using cell-type-specific promoter-driven reporter constructs for the targeted labeling and subsequent isolation of exosomes from specific cell types in vivo from mouse tissues. The differentiation between exosomes and ectosomes remains challenging due to limitations of current isolation techniques that are primarily based on size, density or surface markers. To address this issue, our approach leverages genetic engineering to mark exosomes specifically, enabling their precise identification and isolation from a complex biological pool of heterogenous extracellular vesicles. The isolated cell-type-specific exosomes are characterized by electron microscopy, nanoparticle tracking analysis, antibody exosome array assay and other established techniques. The labeling and isolation of exosomes spans 2–3 days and is designed to be accessible to researchers with fundamental laboratory competencies. This protocol facilitates the study of exosome-mediated cellular communication by enabling the isolation of cell-type-specific exosomes from either individual cell types or multiple cell types in combination. Most experiments within the protocol have used murine wound-edge skin tissue, but the protocol can, in principle, also be applied to other tissues to isolate exosomes, with a few modifications as required. This methodology opens new avenues for exploring the functional roles of cell-type-specific exosomes in intercellular communication.
Key points
-
Exosomes—extracellular vesicles of endosomal origin—are important mediators of cell–cell communications yet are difficult to isolate from the heterogeneous pool of extracellular vesicles using methods based on size, density and surface markers.
-
This protocol uses tissue nanotransfection to deliver reporter constructs driven by cell-type-specific promoters for the immunomagnetic isolation of specific exosome populations from mouse tissue followed by elution with acidic buffer and purification by ultracentrifugation. The resulting exosomes are characterized by established assays.
This is a preview of subscription content, access via your institution
Access options
Access Nature and 54 other Nature Portfolio journals
Get Nature+, our best-value online-access subscription
$32.99 / 30 days
cancel any time
Subscribe to this journal
Receive 12 print issues and online access
$259.00 per year
only $21.58 per issue
Buy this article
- Purchase on SpringerLink
- Instant access to the full article PDF.
USD 39.95
Prices may be subject to local taxes which are calculated during checkout

Similar content being viewed by others
Data availability
The authors declare that the main data discussed in this protocol are available in the supporting primary research paper53. The snapgene files, QC files and service reports of the plasmids are available at Figshare via https://doi.org/10.6084/m9.figshare.26169487.v1 (ref. 99).
References
Zappulli, V., Friis, K. P., Fitzpatrick, Z., Maguire, C. A. & Breakefield, X. O. Extracellular vesicles and intercellular communication within the nervous system. J. Clin. Invest. 126, 1198–high–1207 (2016).
Colombo, M., Raposo, G. & Thery, C. Biogenesis, secretion, and intercellular interactions of exosomes and other extracellular vesicles. Annu. Rev. Cell Dev. Biol. 30, 255–289 (2014).
Faict, S. et al. Exosomes play a role in multiple myeloma bone disease and tumor development by targeting osteoclasts and osteoblasts. Blood Cancer J. 8, 105 (2018).
Hosseinkhani, B., Kuypers, S., van den Akker, N. M. S., Molin, D. G. M. & Michiels, L. Extracellular vesicles work as a functional inflammatory mediator between vascular endothelial cells and immune cells. Front. Immunol. 9, 1789 (2018).
Wang, J. et al. Extracellular vesicle cross-talk in the bone marrow microenvironment: implications in multiple myeloma. Oncotarget 7, 38927–38945 (2016).
Xu, R., Greening, D. W., Zhu, H. J., Takahashi, N. & Simpson, R. J. Extracellular vesicle isolation and characterization: toward clinical application. J. Clin. Invest. 126, 1152–1162 (2016).
Tkach, M. & Théry, C. Communication by extracellular vesicles: where we are and where we need to go. Cell 164, 1226–1232 (2016).
Visnovitz, T. Extracellular vesicles: biology and therapeutic applications. Int. J. Mol. Sci 25, 13034 (2024).
Srivastava, A. et al. Progress in extracellular vesicle biology and their application in cancer medicine. Wiley Interdiscip. Rev. Nanomed. Nanobiotechnol. 12, e1621 (2020).
Lin, J., Yang, Z., Wang, L., Xing, D. & Lin, J. Global research trends in extracellular vesicles based on stem cells from 1991 to 2021: a bibliometric and visualized study. Front. Bioeng. Biotechnol. 10, 956058 (2022).
Kelwick, R. J. R., Webb, A. J., Heliot, A., Segura, C. T. & Freemont, P. S. Opportunities to accelerate extracellular vesicle research with cell-free synthetic biology. J. Extracell. Biol. 2, e90 (2023).
Welsh, J. A. et al. Minimal information for studies of extracellular vesicles (MISEV2023): from basic to advanced approaches. J. Extracell. Vesicles 13, e12404 (2024).
Watanabe, S. et al. Skeletal muscle releases extracellular vesicles with distinct protein and microRNA signatures that function in the muscle microenvironment. PNAS Nexus 1, pgac173 (2022).
Thakur, A. et al. The mini player with diverse functions: extracellular vesicles in cell biology, disease, and therapeutics. Protein Cell 13, 631–654 (2021).
Nelson, B. C. et al. Measurement and standardization challenges for extracellular vesicle therapeutic delivery vectors. Nanomedicine 15, 2149–2170 (2020).
Yadav, A., Xuan, Y., Sen, C. K. & Ghatak, S. Standardized reporting of research on exosomes to ensure rigor and reproducibility. Adv. Wound Care 13, 584–599 (2024).
Rankin-Turner, S. et al. A call for the standardised reporting of factors affecting the exogenous loading of extracellular vesicles with therapeutic cargos. Adv. Drug Deliv. Rev. 173, 479–491 (2021).
Thery, C., Ostrowski, M. & Segura, E. Membrane vesicles as conveyors of immune responses. Nat. Rev. Immunol. 9, 581–593 (2009).
Doyle, L. M. & Wang, M. Z. Overview of extracellular vesicles, their origin, composition, purpose, and methods for exosome isolation and analysis. Cells 8, 727 (2019).
Kalluri, R. & LeBleu, V. S. The biology, function, and biomedical applications of exosomes. Science 367, eaau6977 (2020).
van Niel, G., D'Angelo, G. & Raposo, G. Shedding light on the cell biology of extracellular vesicles. Nat. Rev. Mol. Cell Biol 19, 213–228 (2018).
Jeppesen, D. K., Zhang, Q., Franklin, J. L. & Coffey, R. J. Extracellular vesicles and nanoparticles: emerging complexities. Trends Cell Biol 33, 667–681 (2023).
Pérez-Boza, J., Lion, M. & Struman, I. Exploring the RNA landscape of endothelial exosomes. RNA 24, 423–435 (2018).
Villarroya-Beltri, C. et al. Sumoylated hnRNPA2B1 controls the sorting of miRNAs into exosomes through binding to specific motifs. Nat. Commun. 4, 2980 (2013).
Janas, T., Janas, M. M., Sapoń, K. & Janas, T. Mechanisms of RNA loading into exosomes. FEBS Lett. 589, 1391–1398 (2015).
Creemers, E. E., Tijsen, A. J. & Pinto, Y. M. Circulating microRNAs: novel biomarkers and extracellular communicators in cardiovascular disease. Circ. Res. 110, 483–495 (2012).
Guduric-Fuchs, J. et al. Selective extracellular vesicle-mediated export of an overlapping set of microRNAs from multiple cell types. BMC Genom. 13, 357 (2012).
Zhang, J. et al. Exosome and exosomal microRNA: trafficking, sorting, and function. Genom. Proteom. Bioinform. 13, 17–24 (2015).
Van Deun, J. et al. EV-TRACK: transparent reporting and centralizing knowledge in extracellular vesicle research. Nat. Methods 14, 228–232 (2017).
Van Deun, J. et al. The impact of disparate isolation methods for extracellular vesicles on downstream RNA profiling. J. Extracell. Vesicles 3, 24858 (2014).
Kowal, J. et al. Proteomic comparison defines novel markers to characterize heterogeneous populations of extracellular vesicle subtypes. Proc. Natl Acad. Sci. USA 113, E968–E977 (2016).
Théry, C. et al. Minimal information for studies of extracellular vesicles 2018 (MISEV2018): a position statement of the International Society for Extracellular Vesicles and update of the MISEV2014 guidelines. J. Extracell. Vesicles 7, 1535750 (2018).
Kim, S. Y. et al. Characterization of exosomes and exosomal RNAs isolated from post-mortem body fluids for molecular forensic diagnosis. Diagnostics 12, 2153 (2022).
Guan, S. et al. Characterization of urinary exosomes purified with size exclusion chromatography and ultracentrifugation. J. Proteome Res. 19, 2217–2225 (2020).
Lai, J. J. et al. Exosome processing and characterization approaches for research and technology development. Adv. Sci. 9, e2103222 (2022).
Ekström, K. et al. Characterization of surface markers on extracellular vesicles isolated from lymphatic exudate from patients with breast cancer. BMC Cancer 22, 50 (2022).
Ramirez, M. I. et al. Technical challenges of working with extracellular vesicles. Nanoscale 10, 881–906 (2018).
Willms, E., Cabañas, C., Mäger, I., Wood, M. J. A. & Vader, P. Extracellular vesicle heterogeneity: subpopulations, isolation techniques, and diverse functions in cancer progression. Front. Immunol 9, 738 (2018).
Sharma, A., Yadav, A., Nandy, A. & Ghatak, S. Insight into the functional dynamics and challenges of exosomes in pharmaceutical innovation and precision medicine. Pharmaceutics 16, 709 (2024).
Ahmed, K. A. & Xiang, J. Mechanisms of cellular communication through intercellular protein transfer. J. Cell. Mol. Med. 15, 1458–1473 (2011).
Peinado, H., Lavotshkin, S. & Lyden, D. The secreted factors responsible for pre-metastatic niche formation: old sayings and new thoughts. Semin. Cancer Biol. 21, 139–146 (2011).
Yadav, A., Nandy, A., Sharma, A. & Ghatak, S. in Intercellular and Interorganellar Transfer and Communication in Biology and Medicine (eds Kloc, M., Kubiak, J. Z. & Halasa, M.) 249–297 (Springer, 2024).
Li, X. et al. Challenges and opportunities in exosome research—perspectives from biology, engineering, and cancer therapy. APL Bioeng. 3, 011503 (2019).
Hadizadeh, N. et al. Extracellular vesicles biogenesis, isolation, manipulation and genetic engineering for potential in vitro and in vivo therapeutics: an overview. Front. Bioeng. Biotechnol. 10, 1019821 (2022).
De Sousa, K. P. et al. Isolation and characterization of extracellular vesicles and future directions in diagnosis and therapy. Wiley Interdiscip. Rev. Nanomed. Nanobiotechnol. 15, e1835 (2023).
van de Wakker, S. I., Meijers, F. M., Sluijter, J. P. G. & Vader, P. Extracellular vesicle heterogeneity and its impact for regenerative medicine applications. Pharmacol. Rev. 75, 1043–1061 (2023).
Allelein, S. et al. Potential and challenges of specifically isolating extracellular vesicles from heterogeneous populations. Sci. Rep. 11, 11585 (2021).
Kim, D. K. et al. EVpedia: a community web portal for extracellular vesicles research. Bioinformatics 31, 933–939 (2015).
Keerthikumar, S. et al. ExoCarta: a web-based compendium of exosomal cargo. J. Mol. Biol. 428, 688–692 (2016).
Andreu, Z. & Yáñez-Mó, M. Tetraspanins in extracellular vesicle formation and function. Front. Immunol. 5, 442–442 (2014).
McAndrews, K. & Kalluri, R. Mechanisms associated with biogenesis of exosomes in cancer. Mol. Cancer 18, 52 (2019).
Garcia-Martin, R., Brandao, B. B., Thomou, T., Altindis, E. & Kahn, C. R. Tissue differences in the exosomal/small extracellular vesicle proteome and their potential as indicators of altered tissue metabolism. Cell Rep. 38, 110277 (2022).
Zhou, X. et al. Exosome-mediated crosstalk between keratinocytes and macrophages in cutaneous wound healing. ACS Nano 14, 12732–12748 (2020).
Sharma, A. et al. Mitochondrial bioenergetics of functional wound closure is dependent on macrophage–keratinocyte exosomal crosstalk. ACS Nano 18, 30405–30420 (2024).
Brown, B. A. et al. Analysis of keratinocytic exosomes from diabetic and nondiabetic mice by charge detection mass spectrometry. Anal. Chem. 94, 8909–8918 (2022).
Xuan, Y. et al. Fabrication and use of silicon hollow needle arrays to achieve tissue nanotransfection in mouse tissue in vivo. Nat. Protoc. 16, 5707–5738 (2021).
Van Deun, J., Hendrix, A. & Consortium, E. -T. Is your article EV-TRACKed? J. Extracell. Vesicles 6, 1379835 (2017).
Skalnikova, H. K. et al. Isolation and characterization of small extracellular vesicles from porcine blood plasma, cerebrospinal fluid, and seminal plasma. Proteomes 7, 17 (2019).
Monguió-Tortajada, M. et al. Extracellular-vesicle isolation from different biological fluids by size-exclusion chromatography. Curr. Protoc. Stem Cell Biol. 49, e82 (2019).
Balaj, L. et al. Tumour microvesicles contain retrotransposon elements and amplified oncogene sequences. Nat. Commun. 2, 180 (2011).
Crescitelli, R., Lässer, C. & Lötvall, J. Isolation and characterization of extracellular vesicle subpopulations from tissues. Nat. Protoc. 16, 1548–1580 (2021).
Gheinani, A. H. et al. Improved isolation strategies to increase the yield and purity of human urinary exosomes for biomarker discovery. Sci. Rep. 8, 3945 (2018).
Benmoussa, A., Michel, S., Gilbert, C. & Provost, P. Isolating multiple extracellular vesicles subsets, including exosomes and membrane vesicles, from bovine milk using sodium citrate and differential ultracentrifugation. Bio. Protoc. 10, e3636 (2020).
Lin, A. A., Shen, H., Spychalski, G., Carpenter, E. L. & Issadore, D. Modeling and optimization of parallelized immunomagnetic nanopore sorting for surface marker specific isolation of extracellular vesicles from complex media. Sci. Rep. 13, 13292 (2023).
Brennan, K. et al. A comparison of methods for the isolation and separation of extracellular vesicles from protein and lipid particles in human serum. Sci. Rep. 10, 1039 (2020).
Coughlan, C. et al. Exosome isolation by ultracentrifugation and precipitation and techniques for downstream analyses. Curr. Protoc. Cell Biol. 88, e110 (2020).
Gao, J. et al. Recent developments in isolating methods for exosomes. Front. Bioeng. Biotechnol. 10, 1100892 (2022).
Du, S. et al. Extracellular vesicles: a rising star for therapeutics and drug delivery. J. Nanobiotechnol. 21, 231 (2023).
Zhang, Q., Jeppesen, D. K., Higginbotham, J. N., Franklin, J. L. & Coffey, R. J. Comprehensive isolation of extracellular vesicles and nanoparticles. Nat. Protoc. 18, 1462–1487 (2023).
Rodolfo, C. & Campello, S. Extracellular vesicles and co.: scaring immune cells in the TME since ever. Front. Immunol. 15, 1451003 (2024).
Chen, J. et al. Recent advances in microfluidic-based extracellular vesicle analysis. Micromachines 15, 630 (2024).
Wu, Y. et al. Microfluidic technology for the isolation and analysis of exosomes. Micromachines 13, 1571 (2022).
Bordanaba-Florit, G., Royo, F., Kruglik, S. G. & Falcón-Pérez, J. M. Using single-vesicle technologies to unravel the heterogeneity of extracellular vesicles. Nat. Protoc. 16, 3163–3185 (2021).
Tian, F., Liu, C., Deng, J. & Sun, J. Microfluidic separation, detection, and engineering of extracellular vesicles for cancer diagnostics and drug delivery. Acc. Mater. Res. 3, 498–510 (2022).
Gallart-Palau, X., Serra, A. & Sze, S. K. Enrichment of extracellular vesicles from tissues of the central nervous system by PROSPR. Mol. Neurodegener. 11, 41 (2016).
Hurwitz, S. N., Olcese, J. M. & Meckes, D. G., Jr. Extraction of extracellular vesicles from whole tissue. J. Vis. Exp. https://doi.org/10.3791/59143 (2019).
Hurwitz, S. N. et al. An optimized method for enrichment of whole brain-derived extracellular vesicles reveals insight into neurodegenerative processes in a mouse model of Alzheimer’s disease. J. Neurosci. Methods 307, 210–220 (2018).
Gurunathan, S., Kang, M. H., Jeyaraj, M., Qasim, M. & Kim, J. H. Review of the isolation, characterization, biological function, and multifarious therapeutic approaches of exosomes. Cells 8, 307 (2019).
Jeurissen, S. et al. The isolation of morphologically intact and biologically active extracellular vesicles from the secretome of cancer-associated adipose tissue. Cell Adhes. Migr. 11, 196–204 (2017).
Jingushi, K. et al. Extracellular vesicles isolated from human renal cell carcinoma tissues disrupt vascular endothelial cell morphology via azurocidin. Int. J. Cancer 142, 607–617 (2018).
Nieuwland, R., Siljander, P. R. M., Falcón-Pérez, J. M. & Witwer, K. W. Reproducibility of extracellular vesicle research. Eur. J. Cell Biol. 101, 151226 (2022).
Ortega-Sanchez, F. G. et al. Microfluidic systems in extracellular vesicles single analysis. A systematic review. Trends Anal. Chem. 159, 116920 (2023).
Konoshenko, M. Y., Lekchnov, E. A., Vlassov, A. V. & Laktionov, P. P. Isolation of extracellular vesicles: general methodologies and latest trends. Biomed. Res. Int. 2018, 8545347 (2018).
Guda, P. R. et al. Nanoscopic and functional characterization of keratinocyte-originating exosomes in the wound fluid of non-diabetic and diabetic chronic wound patients. Nano Today 52, 101954 (2023).
Anthony, A. J. et al. CDMS analysis of intact 19S, 20S, 26S, and 30S proteasomes: evidence for higher-order 20S assemblies at a low pH. Anal. Chem. 95, 12209–12215 (2023).
Bertani, G. Studies on lysogenesis I: the mode of phage liberation by lysogenic Escherichia coli. J. Bacteriol. 62, 293–300 (1951).
Lennox, E. Transduction of linked genetic characters of the host by bacteriophage P1. Virology 1, 190–206 (1955).
Islas-Flores, I., Peraza-Echeverría, L., Canto-Canché, B. & Rodríguez-García, C. M. Extraction of high-quality, melanin-free RNA from Mycosphaerella fijiensis for cDNA preparation. Mol. Biotechnol. 34, 45–50 (2006).
Hánělová, K., Raudenská, M., Masařík, M. & Balvan, J. Protein cargo in extracellular vesicles as the key mediator in the progression of cancer. Cell Commun. Signal. 22, 25 (2024).
Bastin, G. & Heximer, S. P. Rab family proteins regulate the endosomal trafficking and function of RGS4. J. Biol. Chem. 288, 21836–21849 (2013).
Campos-Silva, C. et al. High sensitivity detection of extracellular vesicles immune-captured from urine by conventional flow cytometry. Sci. Rep. 9, 2042 (2019).
Khushman, M. et al. Exosomal markers (CD63 and CD9) expression pattern using immunohistochemistry in resected malignant and nonmalignant pancreatic specimens. Pancreas 46, 782–788 (2017).
Xiao, D. et al. Regulation of the function and expression of EpCAM. Biomedicines 12, 1129 (2024).
Li, X. X. et al. The roles of exosomal proteins: classification, function, and applications. Int. J. Mol. Sci. 24, 3061 (2023).
Luo, W. et al. Spatial and temporal tracking of cardiac exosomes in mouse using a nano-luciferase-CD63 fusion protein. Commun. Biol. 3, 114 (2020).
Zhan, Z., Ye, M. & Jin, X. et al. The roles of FLOT1 in human diseases (review). Mol. Med. Rep. 28, 212 (2023).
Zhang, W. et al. ICAM-1-mediated adhesion is a prerequisite for exosome-induced T cell suppression. Dev. Cell 57, 329–343.e327 (2022).
Mosquera-Heredia, M. I. et al. Exosomes: potential disease biomarkers and new therapeutic targets. Biomedicines 9, 1061 (2021).
Ghatak, S. Snapgene files, QC files (plasmid sequencing results), and service reports from ABM. Figshare https://doi.org/10.6084/m9.figshare.26169487.v1 (2025).
Acknowledgements
The TNT chips were fabricated at the Pritzker Nanofabrication Facility, which receives partial support from the SHyNE Resource, a node of the National Science Foundation’s National Nanotechnology Coordinated Infrastructure (grant no. NSF ECCS-2025633). This work was supported by NIH (grant no. DK129592 to S.G. and grant no. GM143572 to Y.X. and in part by grant nos. DK128845 and DK135447 to C.K.S.).
Author information
Authors and Affiliations
Contributions
A.Y. and A.S. designed and performed the TNT procedure on mice and other biological experiments. M.M., P.V.G. and A.N. carried out characterization. Y.X. fabricated and performed quality control on the TNT chip. C.K.S. provided resources and supervision. S.G. conceived of the idea, provided plasmid design guidelines to ABMGood, supervised and led this project. All authors have contributed to writing and editing the manuscript.
Corresponding author
Ethics declarations
Competing interests
The authors declare no competing interests.
Peer review
Peer review information
Nature Protocols thanks Rossella Crescitelli, Ke Cheng and Saman Yasamineh for their contribution to the peer review of this work.
Additional information
Publisher’s note Springer Nature remains neutral with regard to jurisdictional claims in published maps and institutional affiliations.
Key references
Zhou, X. et al. ACS Nano 14, 12732–12748 (2020): https://doi.org/10.1021/acsnano.0c03064
Brown, B. A. et al. Anal. Chem. 94, 8909–8918 (2022): https://doi.org/10.1021/acs.analchem.2c00453
Sharma, A. et al. ACS Nano 18, 30405–30420 (2024): https://doi.org/10.1021/acsnano.4c07610
Xuan, Y. et al. Nat. Protoc. 16, 5707–5738 (2021): https://doi.org/10.1038/s41596-021-00631-0
Supplementary information
Supplementary information (download PDF )
Supplementary Note 1.
Rights and permissions
Springer Nature or its licensor (e.g. a society or other partner) holds exclusive rights to this article under a publishing agreement with the author(s) or other rightsholder(s); author self-archiving of the accepted manuscript version of this article is solely governed by the terms of such publishing agreement and applicable law.
About this article
Cite this article
Yadav, A., Sharma, A., Moulick, M. et al. Labeling, isolation and characterization of cell-type-specific exosomes derived from mouse skin tissue. Nat Protoc 21, 1192–1234 (2026). https://doi.org/10.1038/s41596-025-01238-5
Received:
Accepted:
Published:
Version of record:
Issue date:
DOI: https://doi.org/10.1038/s41596-025-01238-5


